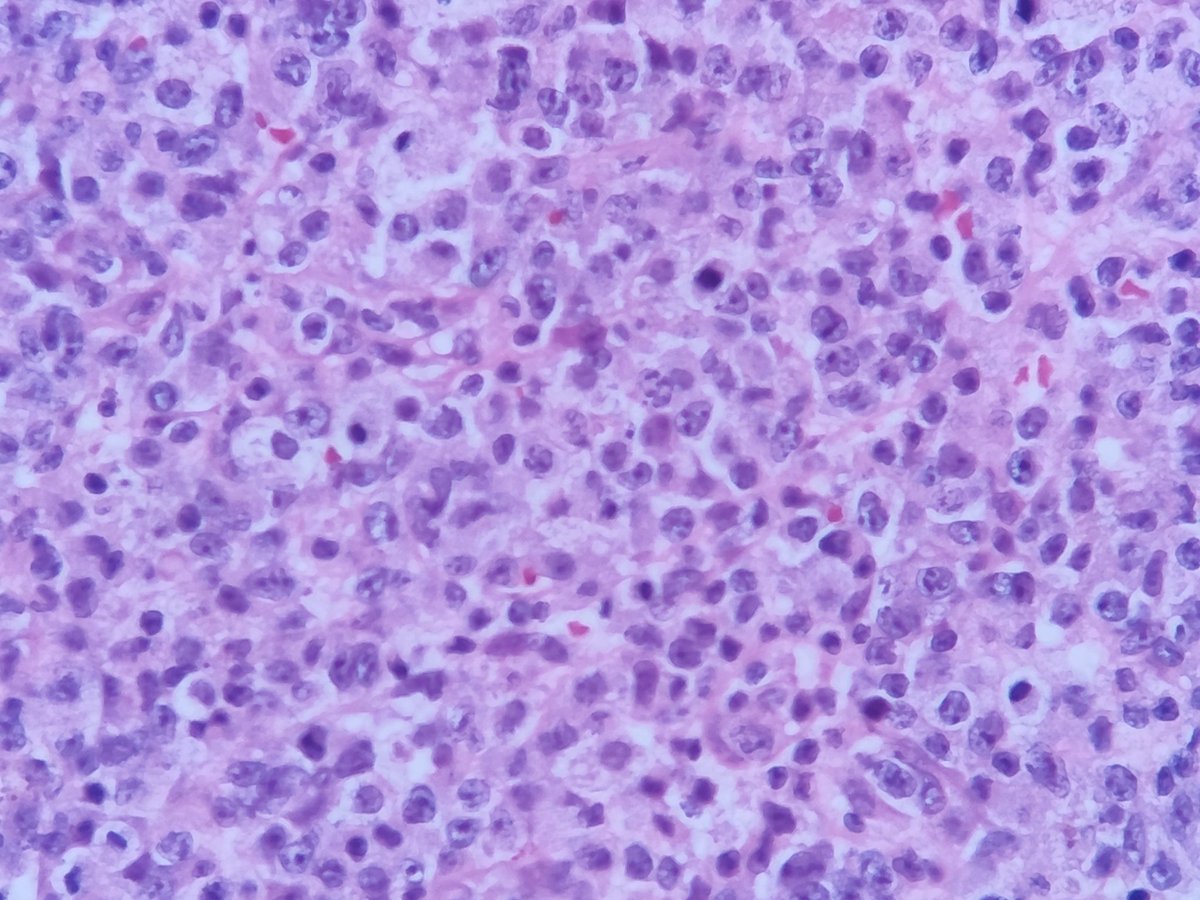
T.JeffLimMD tweet media
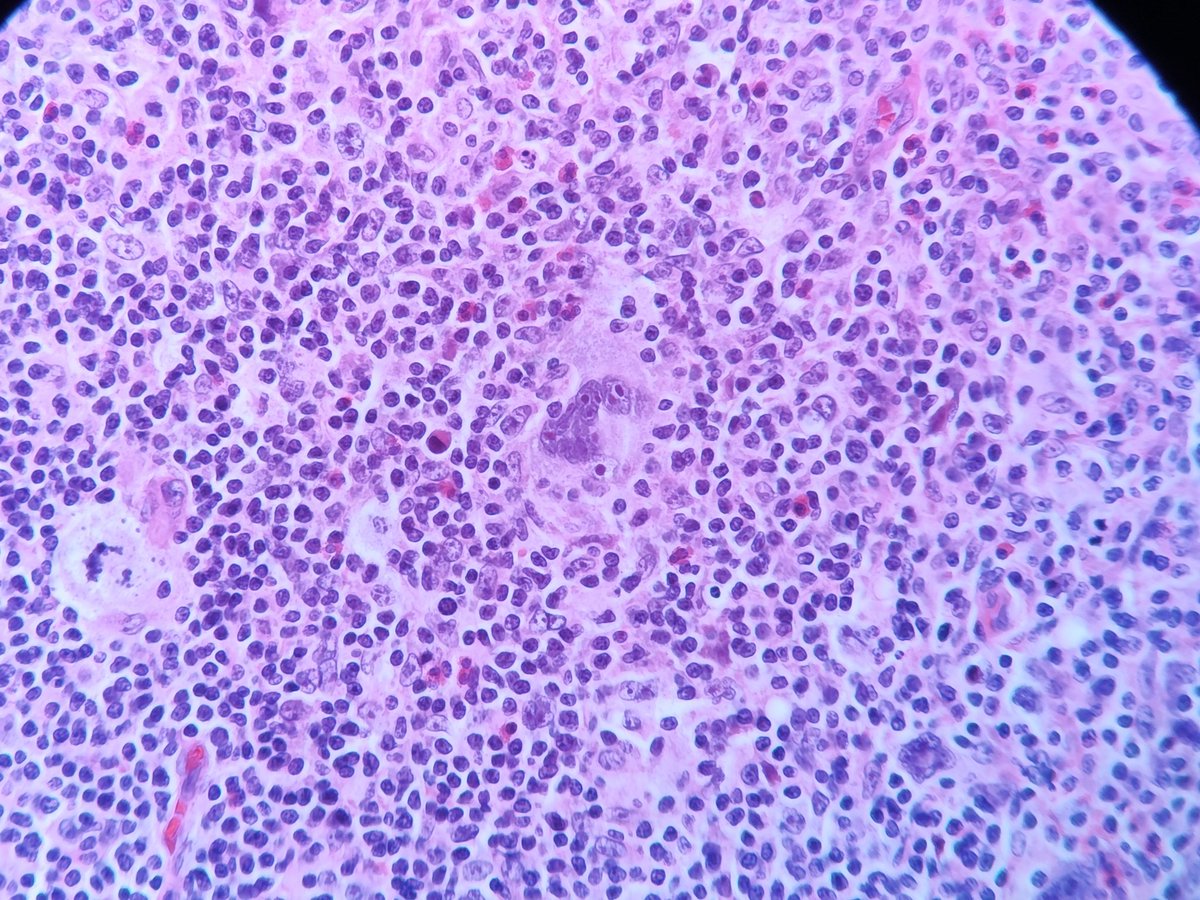
T.JeffLimMD tweet media

T.JeffLimMD
2.2K posts


T.JeffLimMD
@TjLimMD
Pathologist, X mostly heme cases. Did Heme works at UHN, Tech addict. Dog Sitter. 🌝
🇵🇭 Manila, Ph Katılım Kasım 2017
448 Takip Edilen820 Takipçiler

I don't really see these cases as often as I should. Can't help feel excited 😆
#heme #Hematology #hematopathology

English

@MeredithKHerman @leon_metlay @UMichPath I can only agree on the 80 to 100 mark... 😁 Tough way to make an assessment.
English

How do you determine bone marrow cellularity?…it’s a vibe, or is it? Made this diagram today to help my PGY1 brain solidify the “vibes” of hemepath #hemepath #PathTwitter #pathx #pathstudytips @UMichPath

English

@zhang_xuchen @kitagawa_yukiko @Teclis82 Is it possible to have normal or reactive proliferation of mast cells like that?
English
T.JeffLimMD retweetledi

I'm working on a teaching presentation on Hodgkin's lymphoma.
Picture below contains HRS-like cells from 9 different cases.
Which ones are classical Hodgkin's lymphoma and which ones are something else?
#hemepath #pathtwitter #pathology

English
T.JeffLimMD retweetledi
T.JeffLimMD retweetledi

Workup of high-grade B-cell lymphoma/diffuse large B-cell lymphoma
- Establish cell of origin: Hans algorithm
- Assess for double-expressor lymphoma (DEL): MYC and BCL2 IHC
- Assess for double-hit lymphoma (DHL): FISH for MYC, BCL2, and BCL6
Dr. Sohani - 46th Annual Current Concepts in Surgical Pathology


English

Quandary over atypia. How can you really tell? My tolerance has always been high but I've known someone who cries atypia at the slightest hint of uncomfy clearing.
What's your criteria? #gynepath




English
T.JeffLimMD retweetledi

If you diagnose a nodal T-cell lymphoma with these features:
-Morphology is blastoid
-No monotypic pattern of TRBC1 by flow cytometry analysis
-No TCR gene rearrangement by PCR
Add a marker of cell immaturity like TDT, CD34, CD117 etc, even if the clinical features are not screaming T-ALL, not to miss a myeloid/lymphoid neoplasm with eosinophilia and tyrosine kinase gene fusions.
This group of diseases is rare and driven by rearrangements of PDGFRA, PDGFRB, FGFR1, JAK2, FLT3, and ETV6::ABL1 fusion.
Although eosinophilia seems to be always present, some cases may lack it, which can create a great diagnostic pitfall.
The clinicopathological features of this group of diseases are quite heterogeneous, presenting as chronic eosinophilic leukemia NOS, MDS/MPN, MDS, MPN, systemic mastocytosis, T-ALL, B-ALL, AML, blastic phase of MPN, or MPAL.
Extramedullary involvement at diagnosis or during progression is common.
Below pictures of a case of myeloid/lymphoid neoplasm with ETV6::FLT3 fusion with nodal involvement at presentation and no associated eosinophilia, are from
➡️pubmed.ncbi.nlm.nih.gov/37985498/
#Hemepath #PathX #Pathtwitter #Leusm #lymsm



English
T.JeffLimMD retweetledi

📊 Staging Cancer in Colonic Polyps 🔬
1️⃣ Polyp type: Stalked vs Sessile 🧐
2️⃣ Classification: Haggitt 🏷️ | Kikuchi 📏
Master staging & predict invasion risk like a pro! 🩺✨
#ColorectalPathology #Histopathology #FRCPathPrep #PolypCancer #ExamPrep #PathologyMastery




English
T.JeffLimMD retweetledi

(5/5) Features of plasmablastic lymphoma and differential diagnosis of lymphomas with plasmacytic features
#hemepath #hemepathmda #virtualpath #virtualhemepathmda




English
T.JeffLimMD retweetledi

Another of #hemepath 🩸 🔬marathon in the books, on the new #Leukemia service. Here’s a select handful of interesting cases I saw today… 🧵
1. Acute erythroid leukemia, TP53 mutated.
Note the elongated “carrot – like” nucleoli, often membrane-bound (arrow) on H&E, the large blast with raw nuclei and deeply basophilic cytoplasm with vacuoles on the smear, and the P 53 IHC showing strong nuclear over expression (mutant pattern). By flow, the blast were CD117 +, CD123 - and CD36 bright + with partial CD 34 expression.



English

@sanamloghavi @ZhuoerXie @Stanford Definitely a big thanks to my mentors at Toronto General Hospital, Drs Jiong Yan , Delabie, Xia, Chang, Reis, Sakhdari, Tierens, they took a chance on an overseas fellow at the height of COVID19 epidemic.
English

Amazing @ZhuoerXie ♥️
Most of us are here today because someone was kind and generous enough to take a chance on us. For me it was Eugene Butcher at @Stanford … 😍
I remember sending this email like it was yesterday… (2007)
I sent 100+ emails and he was the only person that answered

Zhuoer (Zoey) Xie, MD, MSCR@ZhuoerXie
Still remember arriving in the US, calling every number I could find for an observer opportunity. Today I helped an IMG resident shadow at @MoffittNews —and seeing her hope and energy felt like looking at myself just yesterday. Grateful to pay it forward⏩⏩⏩
English

@sza_jhcyto @whosainastro Heard it, seen it, read it.. but not sure what it can do that I can't fix by moving the stage , focusing and raising and lowering the condenser by trial and error..
English

Nearly 9 of 10 Pathology trainees in my experience have no idea of “Köhler illumination”, an important step in optimizing microscopy by evenly illuminating the field of view. The procedure, which revolutionized microscopy design and use was invented by the German scientist, “August Karl Johann Valentin Köhler” (1866 – 1948).

English